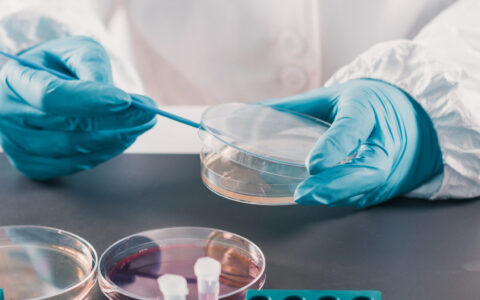

As Omni Danışmanlık, we are always with you to provide fast and reliable services in terms of regulation and legislation for your cosmetic products that you will supply to the Turkey, Europe and United Kingdom!
Regulation Services for Turkey, Europe and United Kingdom
- Formulation/Ingredient Evaluation
- CPSR Part A&B ( Safety Assessment Report )
- Label & Claim Evaluation
- PIF Preparation ( Product Information File )
- Cosmetic Product Notification for UTS, CPNP & SCPN
References







Blog